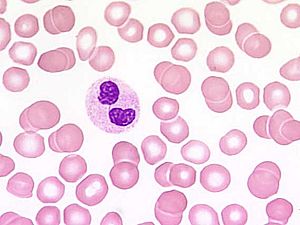
Hämatologie5

Der Römische Mars entspricht dem Griechischen Ares: Kriegsgott schlechthin. Er symbolisiert die unzähmbare männliche Energie. Seine Farbe ist Rot.
Mit Impulsiver Kraft explodiert die Natur zu Beginn des Astrologischen Jahres.
Die Lanze war sein Symbol, ensprechend sein Planetenzeichen mit dem scharfen Pfeil.
Mars (Maurs, Mavors, Marmar)- Kraft, aktive Wirksamkeit, Impuls
Der römische Kriegsgott , war bei den Italischen Stämmen zugleich ein Gott des Wachstums, ein Beschützer der Felder und Herden, ja ein Gott der Weissagung. Die Lanze war sein Symbol. In schweren Kriegen und bei Seuchen gelobte die Gemeinde ihrem Mars einen "heiligen Lenz", d.h. alle im nächsten Frühling vorkommenden Geburten von Mensch und Vieh. Als dem Frühlingsgott war ihm auch der März, ehemal s der erste Monat des Jahres geweiht.
Der griechische Ares- unersättlich im Kampfe nach Homer. Dargestellt als bärtiger, kräftiger Mann, vollständig bewaffnet mit drohender Miene.
Ungeachtet seines finsteren Charackters war Ares der Liebe sehr zugänglich und lag in den Fesseln der Liebesgöttin Aphrodite. Aktiv gelebte Sexualität, Trieb und erotisches Verlangen, auch das sind marsische Themen. Mars ist der "alte,traditionelle Planetenherrscher des Zeichens Skorpion. Im Herbstzeichen Skorpion gehts um die nach innen kehrende Sexuelle Energie. Dies gibts auch heute noch zu beachten, auch wenn der neue Herrscher des Skorpions der Planet Pluto ist.
Im schroffen Gegensatz zu Venus mit ihre Streben nach Harmonie und Ausgleich ist die Gestaltkraft Mars reine expansive motorische Energie, kinetische Energie, die sich voller Dynamik entladen will, ungehemmt durch Rücksichten, die geradlinig auf dem direktesten Weg zum Ziel führen, alles überrennen, was sich ihr dabei in den Weg stellt.
Bewegungsdrang, Bewegungsfreude, Lust und Motivation am Tun, an dem sich unser bewusster Wille entwickelt, der verändert, formend und gestaltend in die Welt eingreift oder Bestehendes zerstört, wenn es ihn einengt oder Widerstand bietet.
"Der Handelnde ist immer gewissenlos". Goethe
"Krieger bin ich und aus dem Kampfe gehe ich siegreich hervor." Das ist der Saatgedanke des Marsischen Widders.
Medizinisch:
Der Mars steht medizinisch für die Abwehr, die Leber und den Pankreas, die Milz und das Immunsystem.
Das Immunsytem: Wie und mit welcher Aktivität unterstützte ich mein Immunsystem? Was tut mir gut? Wo steht der Mars in meinem Horoskop, wie ist er aspektiert. Der Planet Mars steht in diesem Zusammenhang für akute Prozesse. Fieber, Verbrennungen, plötzlich auftretende Entzündungen, akute Herz- Kreislaufprobleme sind marsische Themen.
Das Immunsystem ist wie eine Armee aufgestellt: Die Front stellen die Neutrophilen Granulozyten, die 2. Reihe die T-Helferzellen, die Vermittlung unter den beiden die Monozyten und zuletzt die letzte Instanz die T-Memoryzellen und die Antikörperbildenden B-Zellen, in aktiver akuter Form: die Plasmazelle.
Als Med.Laborantin in Hämatologie, Immunologie und Mikrobiologie, ist dieses Thema für mich besonders interessant.
So akut ein marsischer Krankeitsprozess auch kommen mag, so schnell ist meist auch der Heilungsprozess. Für ein gutes Immunsystem, das wie kaum ein anderes Körpersystem so eng mit der Psyche verbunden, ist ein starker guter Mars Gold wert.